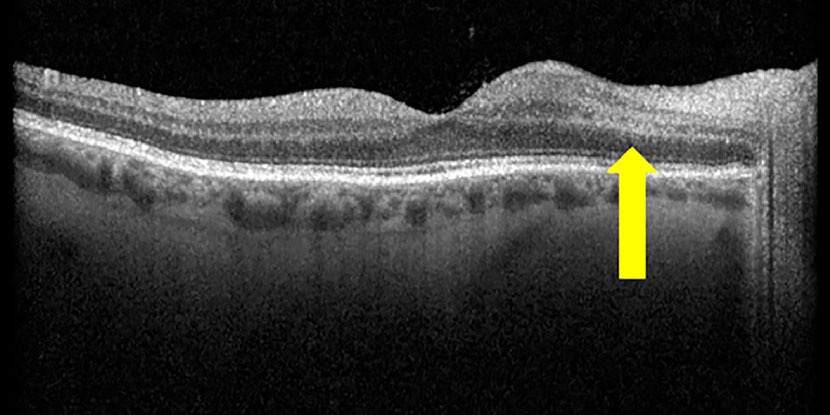

OCT Biomarkers: NAION vs AAION
Do you know what to look for?...
Paracentral acute middle maculopathy (PAMM) and retinal fluid may serve as high-yield biomarkers in distinguishing between arteritic anterior ischemic optic neuropathy (AAION) and non-arteritic anterior ischemic optic neuropathy (NAION). It appears the presence of PAMM and retinal fluid correlates differently with AAION vs NAION, providing us with a potential non-invasive method for differentiation.
Individuals with ischemic optic neuropathy, the presence of PAMM and the absence of peripapillary intraretinal or subretinal fluid on OCT correlated with giant cell arteritis and AAION. However, the presence of peripapillary intraretinal or subretinal fluid extending into the macular region correlated with a non-arteritic etiology, NAION.
For us, this is an opportunity to enhance diagnostic accuracy and streamline decision making. Considering these are potential biomarkers found with standard OCT, we may be able to more quickly and accurately identify the specific type of ischemic optic neuropathy, leading to more targeted and effective management of the underlying source - which can be not only vision saving but life saving.
-JRM
Go to article in AJO, American Journal of Ophthalmology: HERE
VISION & NEUROLOGY CASEBOOK BUNDLE
NEW! Downloadable Book & Podcast Bundle
Whether you’re an optometrist, ophthalmologist, family physician, or simply fascinated by the science of vision and the brain, this casebook and podcast provides practical insights and real-world scenarios which will enhance your clinical knowledge.
Check out the Downloadable Book & Podcast Bundle (with bonuses)!...
PUBLISH YOUR EXPERIENCE
BUILD A CE/CME ONLINE COURSE FROM MATERIAL YOU ALREADY HAVE!
-
No Fees: We'll build & publish your course on our powerful platform.
-
Income Stream: We do the work & you earn.
-
Real Partnership: Real humans.
-
Utilize Existing Materials: Notes, FAAO papers, writings collecting dust?
-
Share Your Expertise: Teach others to help others.
-
Global Audience: Reach eager learners worldwide.
-
Advance Your Career: Contribute to ophthalmic medical education.







Responses